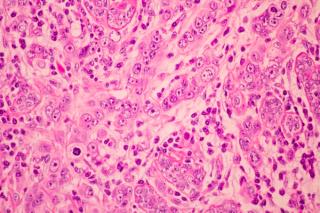

Breast Cancer
Latest News
Latest Videos
CME Content
More News

Focusing on metastatic breast cancer, Aimee Keegan, PharmD, BCOP, provides clinical insights on ensuring optimal adherence to CDK4/6 inhibitors.

The recent ODD for the utidelone injectable could offer another treatment option for patients with BCBM.

Precision oncology represents an evolution in therapeutic practice.

Trastuzumab deruxtecan and elacestrant represent important new treatment options.

Pharmacy Times provides a comprehensive recap of the latest advancements in hematology and breast cancer, shared at the 2023 American Society of Hematology and the San Antonio Breast Cancer Symposium conferences

No established standard of care currently exists after spread to the lymph nodes.

A risk-stratification screening approach that considers screening at an earlier age based on risk factors might increase the likelihood of catching the cancer before it turns symptomatic.

A recent study sheds light on an alarming number of hormone-disrupting chemicals that are found in everyday settings.

Patients should work with clinicians to discuss controlled ovarian stimulation because there is still limited research.

This RNA type might act as an onco-suppressor, and higher levels may indicate better prognosis.

Significant study results could inform clinical practice strategies.

2023 was an impactful year for the field of oncology pharmacy.

The separation between those who travel for care compared to those who go to the local hospital may drive inequalities in health care.

The therapy sustained IDFS benefit compared with ET alone.

Heather McArthur, MD, clinical director of breast oncology at UT Southwestern Medical Center, discusses the toxicities associated with antibody-drug conjugates (ADCs) used in breast cancer treatment at the 2023 San Antonio Breast Cancer Symposium.

Almost 80% of patients have now stopped treatment with ribociclib, but benefit persists and is greater than it was 6 months ago, according to the presenter.

Study results indicate insignificant differences between PFS and OS in patients with HR[+]/HER2[-] breast cancer who received either palbociclib-letrozole or palbociclib-fulvestrant treatment.

As the use of sequencing, proteomics, and immunopeptidomics increases, more targets will also be discovered, as well as more biomarkers that predict responses to treatments.

Individuals with HR+ breast cancer could pause endocrine therapy for up to 2 years to become pregnant, without increasing the risk of recurrence.

Carly Giavatto, PharmD, discusses the CPS conducted study that highlights a first of its kind linkage to care initiative performed by health systems specialty pharmacists.

The investigational combination also delayed the median time to first chemotherapy in all age groups.

Patients with breast cancer who underwent chemotherapy and skipped RNI did not face an increased risk of disease recurrence or death 5 years post-surgery.

Trastuzumab deruxtecan and elacestrant both represent important new treatment options for subgroups of patients with breast cancer.

In the first-line setting, inavolisib plus palbociclib and fulvestrant improved PFS in patients with HR-positive breast cancers; however, further research is needed to understand the trends in OS.

Pharmacy Times will be covering the 2023 San Antonio Breast Cancer Symposium (SABCS), happening December 5 through 9 in Texas.